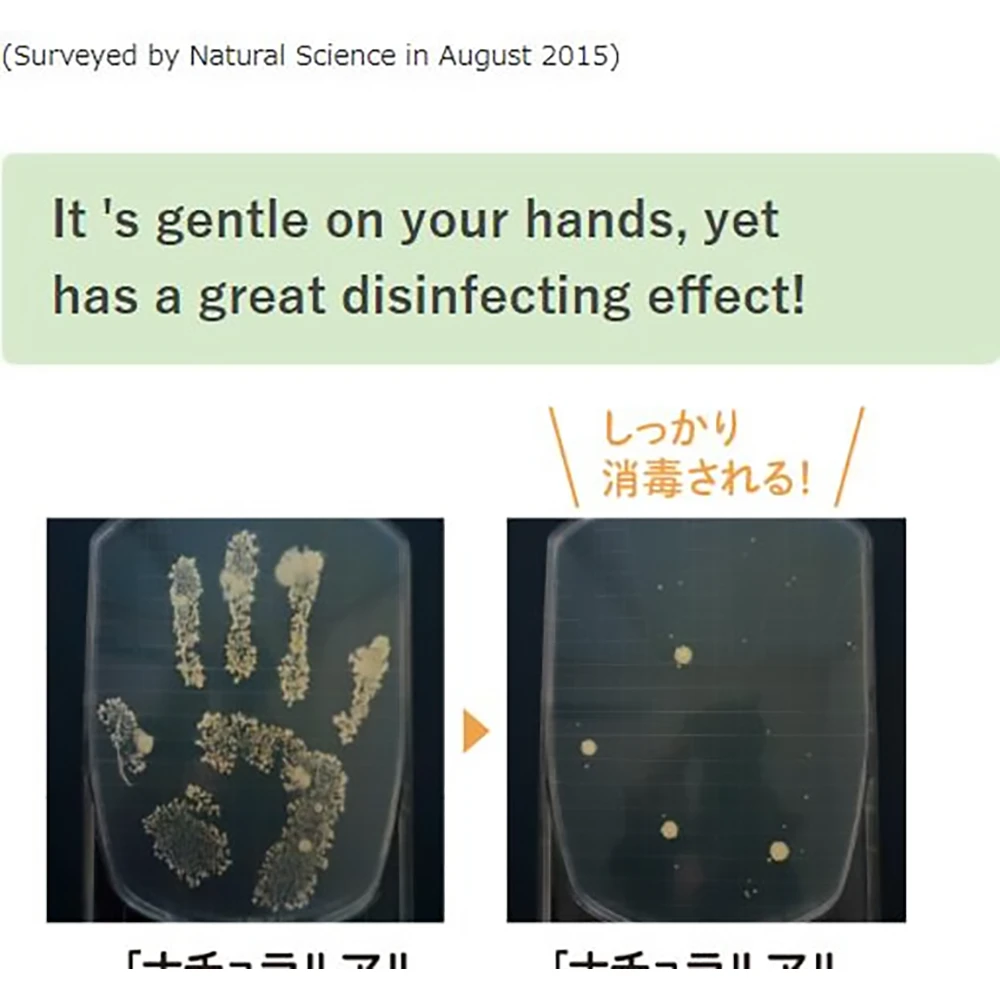

Mama & Kids Natural Alcohol Gel 296ml Mamakids免洗洗手液免洗啫喱296ml大瓶装 无刺激无添加 杀菌免洗洗手液 儿童免洗洗手液 宝宝免洗洗手液
AUD$24.11 – AUD$27.46Price range: AUD$24.11 through AUD$27.46
For Baby
大瓶装链接
免洗型洗手液,无香料,蕴含多种植物保湿精华,天然成分的杀菌,温和配方,天然无添加,杀菌的同时不会伤害孩子娇嫩的双手
滋润保湿,按压式设计,保证内部啫喱的清洁
-
Australian dollar (AUD$) - AUD
- Japanese yen (JPY¥) - JPY
- Canadian dollar (CAD$) - CAD
- Chinese yuan (RMB¥) - CNY
- Euro (EUR€) - EUR
- Pound sterling (GBP£) - GBP
- Hong Kong dollar (HKD$) - HKD
- South Korean won (KRW₩) - KRW
- New Zealand dollar (NZD$) - NZD
- Thai baht (THB฿) - THB
- New Taiwan dollar (TWD$) - TWD
- United States (US) dollar (USD$) - USD
Description
Brands:
Mama & Kids
Additional information
| Weight | N/A |
|---|---|
| type | Fast Shipping ( 10 – 20 days ), Slow Shipping ( 8-10 weeks ) |
Related products
-
Brands:Other其他Add to cart
-
Brands:Betta贝亲Add to cart
-
Brands:UNIQLO优衣库Select options
-
Brands:UNIQLO优衣库Select options

![Betta Baby Bottle [Brain] G4-280Ml 3Rd Anniversary Betta Baby Bottle [Brain] G4-280Ml 3Rd Anniversary](https://pics.suntomarket.com/wp-content/uploads/2023/04/MF230416simp19506p001.webp)



